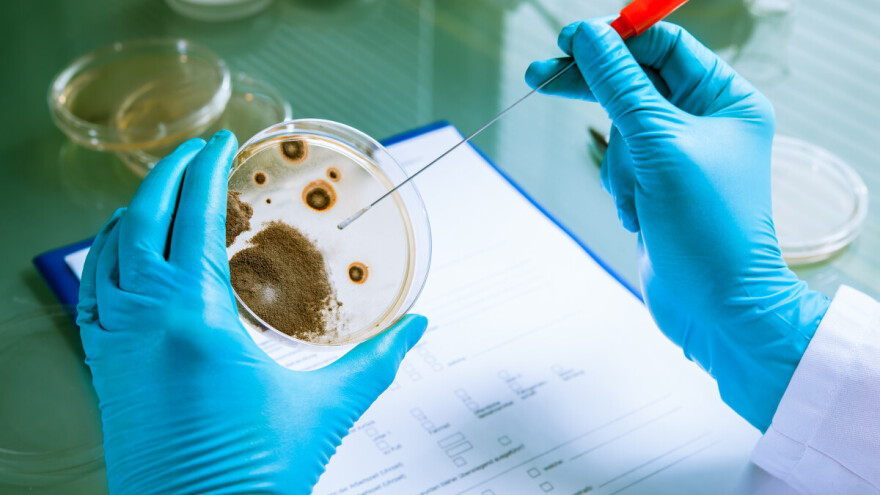

Biološki uzorak koji su američki tužitelji okarakterizirali kao "opasan biološki patogen", a koji je navodno prokrijumčarila kineska znanstvenica, zapravo je uobičajena gljivica koja je već više od stoljeća prisutna na američkim poljima i vjerojatno ne predstavlja ozbiljnu prijetnju sigurnosti hrane, tvrde stručnjaci.
Dvoje kineskih državljana optuženo za agroterorizam - krijumčarili opasan patogen u SAD?
Američko državno odvjetništvo u utorak je optužilo dvoje kineskih istraživača za pokušaj krijumčarenja uzoraka gljivice Fusarium graminearum u SAD, opisujući ju kao potencijalno biološko oružje koje bi se moglo upotrijebiti u terorističke svrhe protiv američke poljoprivrede.
Optužena je Yunqing Jian (33), znanstvenica na Odjelu za molekularnu, staničnu i razvojnu biologiju Sveučilišta Michigan, za koju se tvrdi da je pomogla svom partneru Zunyongu Liuu (34) u pokušaju krijumčarenja gljivice u zemlju.
No, stručnjaci iz područja agronomije za Reuters su izjavili kako je riječ o gljivici koja je već dugo prisutna na američkim farmama, lako se suzbija fungicidima i predstavlja rizik jedino ako se njene toksine unosi redovito i u velikim količinama.
"Kao oružje, bila bi prilično neučinkovita", rekla je prof. Jessica Rutkoski, stručnjakinja za genetiku i oplemenjivanje pšenice sa Sveučilišta Illinois. Dodaje kako bi bilo iznimno teško ciljano izazvati infekciju ovom gljivicom, s obzirom na postojeće prakse testiranja i zaštite u poljoprivredi. Američko državno odvjetništvo i FBI odbili su komentirati upit Reutersa.
Da podsjetimo, Jian se u utorak pojavila pred saveznim sudom u Detroitu, gdje je optužena za zavjeru s ciljem počinjenja kaznenog djela, krijumčarenje robe, davanje lažnih izjava i viznu prijevaru. Nije se očitovala o optužbama, a njezin odvjetnik nije bio dostupan za komentar. Rasprava o jamčevini za Jian zakazana je za 13. lipnja.